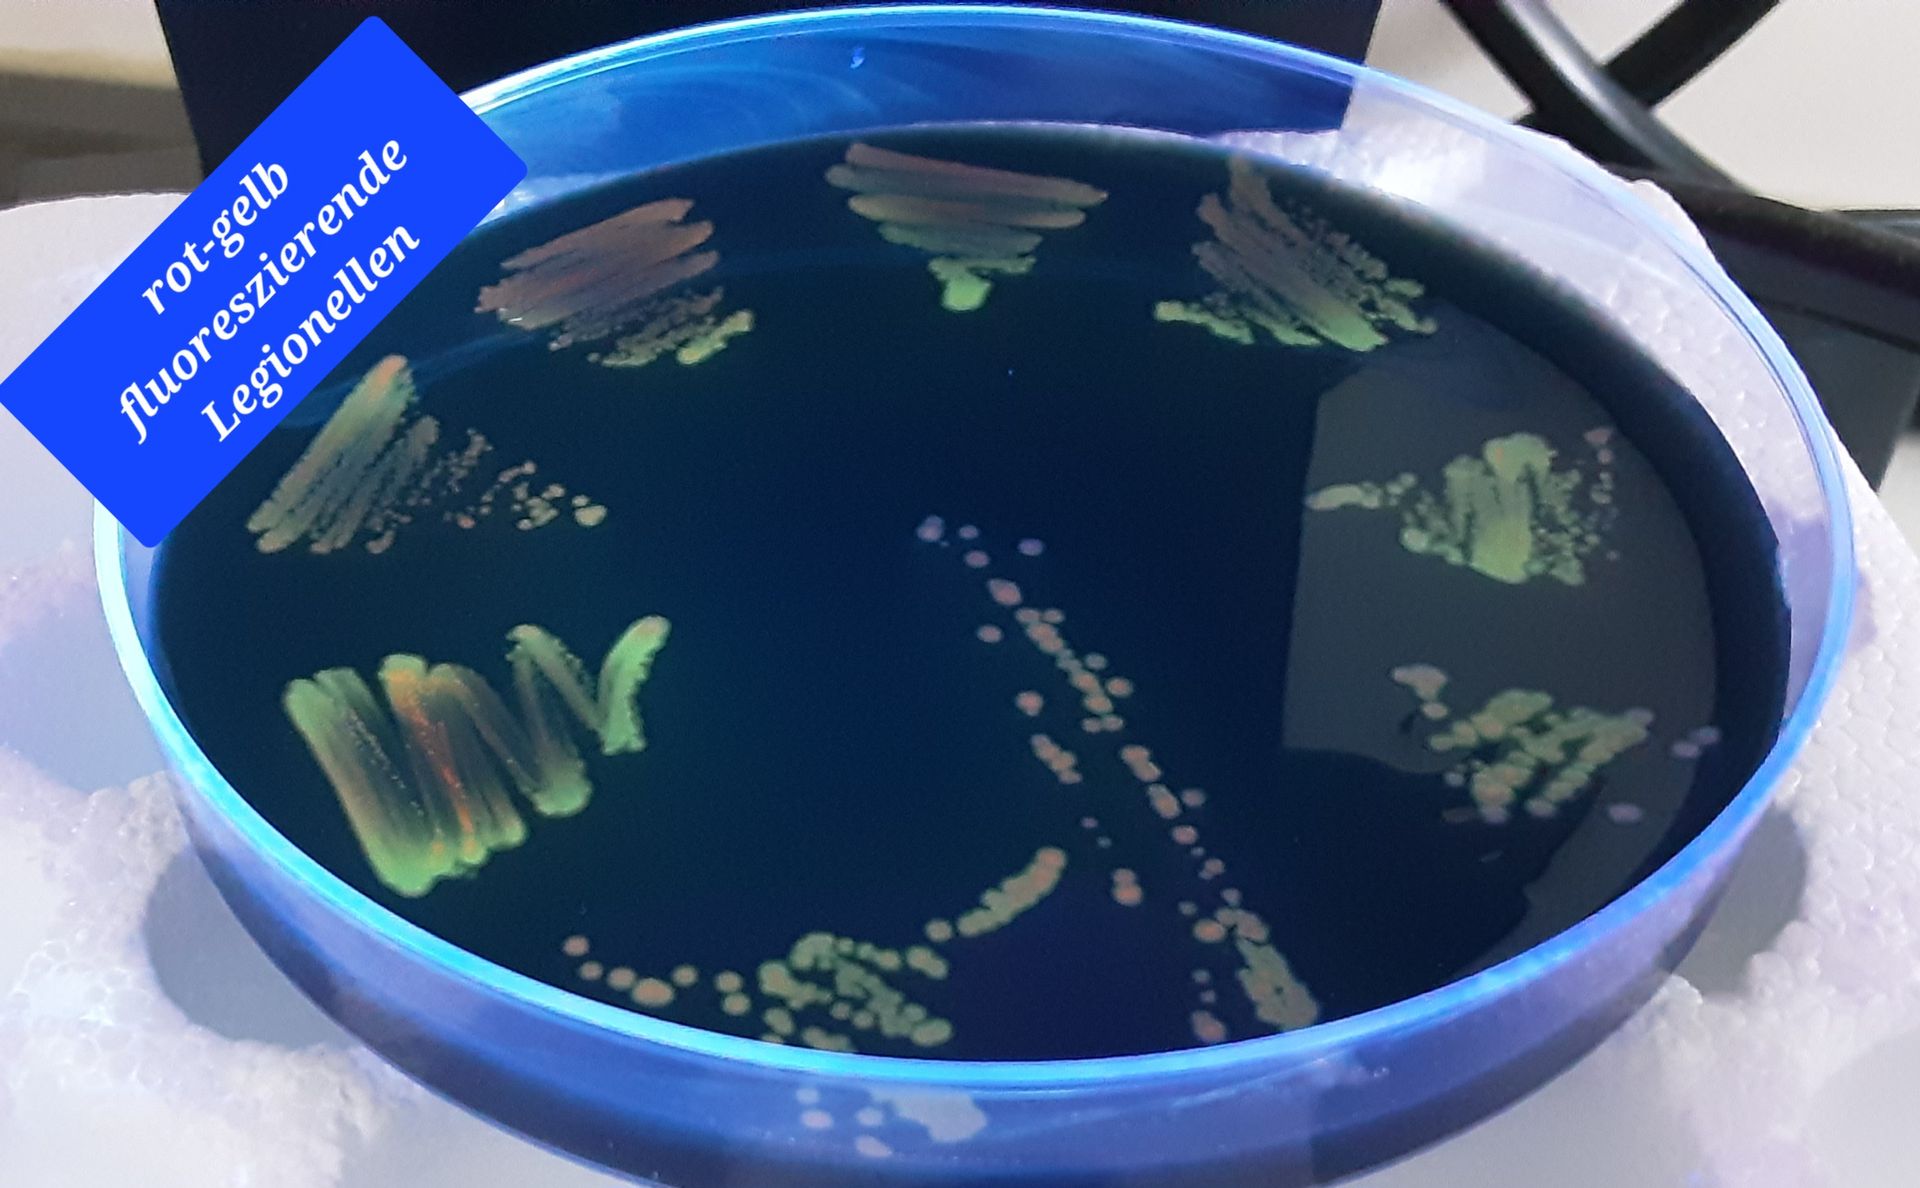
Petrischale mit farbigen Bakterienkolonien auf dunklem Agar unter blauem Etikett

Wasseranalytik und Wasseruntersuchungen
Zuverlässige Analysen für Trinkwasser, Abwasser und technische Wässer
Die LWU Lebensmittel-, Wasser- und Umwelthygiene GmbH ist Ihr kompetenter Ansprechpartner für Wasseranalysen, Probenahmen und hygienische Untersuchungen. Wir analysieren unterschiedlichste Wasserarten nach den jeweils geltenden gesetzlichen Vorgaben und normierten Verfahren. Unser Leistungsspektrum umfasst unter anderem die Untersuchung von Trink- und Brunnenwasser, Legionellenprüfungen, Abwasseranalysen sowie die Überwachung von Kühl- und Badebeckenwasser. Neben der Durchführung der Analysen unterstützen wir Sie mit einer individuellen Beratung bei der Auswahl der passenden Untersuchungen und begleiten Sie bei der Einhaltung gesetzlicher Anforderungen.

Trink- & Brunnenwasser
Wir untersuchen Trink- und Brunnenwasser gemäß Trinkwasserverordnung auf mikrobiologische, chemische und physikalische Parameter und unterstützen Sie bei der Einhaltung gesetzlicher Vorgaben.
Legionellenprüfung
Wir führen systemische Untersuchungen von Warmwasserversorgungsanlagen auf Legionellen durch und unterstützen Sie bei der Einhaltung gesetzlicher Prüf- und Meldepflichten.

Abwasseranalytik
Wir analysieren Abwasser entsprechend wasserrechtlicher Vorgaben und behördlicher Auflagen und liefern zuverlässige Ergebnisse zur Überwachung und Dokumentation Ihrer Anlagen.

Kühlwasseranalysen
Wir untersuchen Kühlwasser gemäß 42. BImSchV auf mikrobiologische Parameter und unterstützen Sie bei der sicheren Überwachung Ihrer Anlagen und der Einhaltung gesetzlicher Anforderungen.

Schwimm- & Badebeckenwasser
Wir prüfen Schwimm- und Badebeckenwasser nach DIN 19643 auf hygienische und chemische Parameter und sorgen für eine sichere Wasserqualität in öffentlichen und privaten Anlagen.

Weitere Wasseranalysen
Sie benötigen eine spezielle Wasseruntersuchung, die hier nicht aufgeführt ist? Wir beraten Sie individuell und finden gemeinsam die passende Analyse für Ihre Anforderungen.
